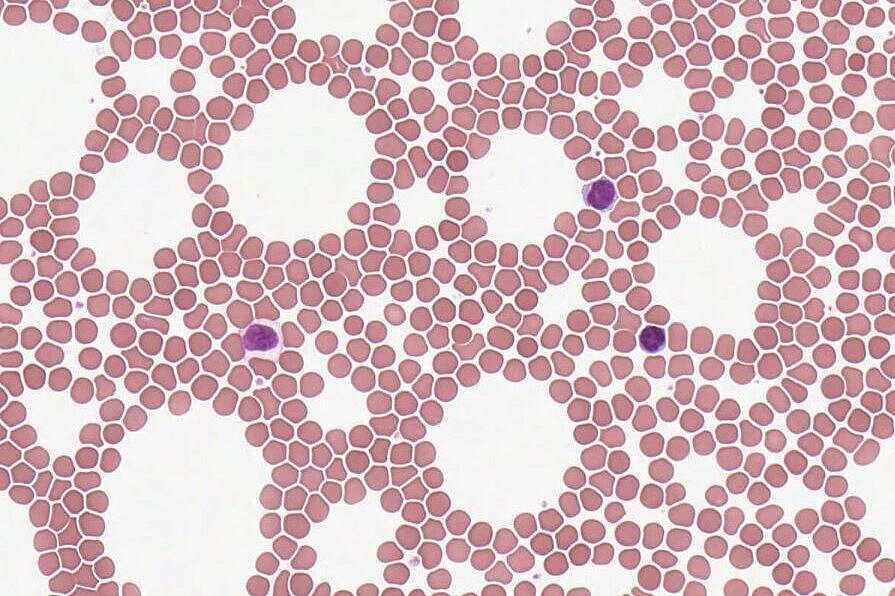

Untenstehend finden Sie die angebotenen Lehrmodule von MicroObserve. Jedes Modul umfasst die MicroObserve-Anwendung als virtuelles Mikroskopie Tool mit den modulspezifischen Präparaten. Modulabhängig finden Sie ggf. noch weitere Arbeitsmaterialien zum Download. Bitte beachten Sie, dass einige Module Passwortgeschützt sind. Die modulspezifischen Zugangsdaten erhalten Sie bei Ihrem*r Dozent*in. Sollten Sie Fragen haben oder ein eigenes Modul anlegen wollen, kontaktieren Sie und gerne.
Modulverantwortlich: Arbeitskreis für Didaktik der Biologie, Prof. Paul W. Dierkes
Veranstaltung: ohne Zugehörigkeit
Der Zugriff benötigt ein Passwort!

Modulverantwortlich: Arbeitskreis für Didaktik der Biologie, Prof. Paul W. Dierkes
Veranstaltung: ohne Zugehörigkeit
Der Zugriff benötigt ein Passwort!